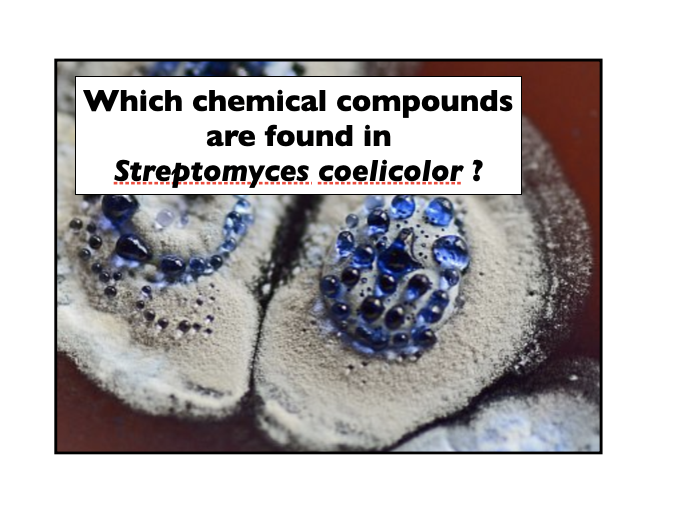
Natural Products tweet media

Sabitlenmiş Tweet

Give SPARQL queries a try ! Here, w.wiki/33WG, we ask LOTUS data in Wikidata for compounds found in 𝘚𝘵𝘳𝘦𝘱𝘵𝘰𝘮𝘺𝘤𝘦𝘴 𝘤𝘰𝘦𝘭𝘪𝘤𝘰𝘭𝘰𝘳
(click the blue arrow on the lower left)
#lotus #openscience #wikidata #naturalproducts

English
Natural Products
1.4K posts


@NatprodCbn
“A recompilation of news and links about natural products, organic chemistry and science more generally ...”

Congrats to Adriano Rutz, @ms_sorok, and colleagues!! 🎉 Great to see this long anticipated collaborative effort out as preprint! So useful for so many #omics applications #metabolomics! 😎 #naturalproducts #taxonomy #structures #database #openacces 😎biorxiv.org/content/10.110…